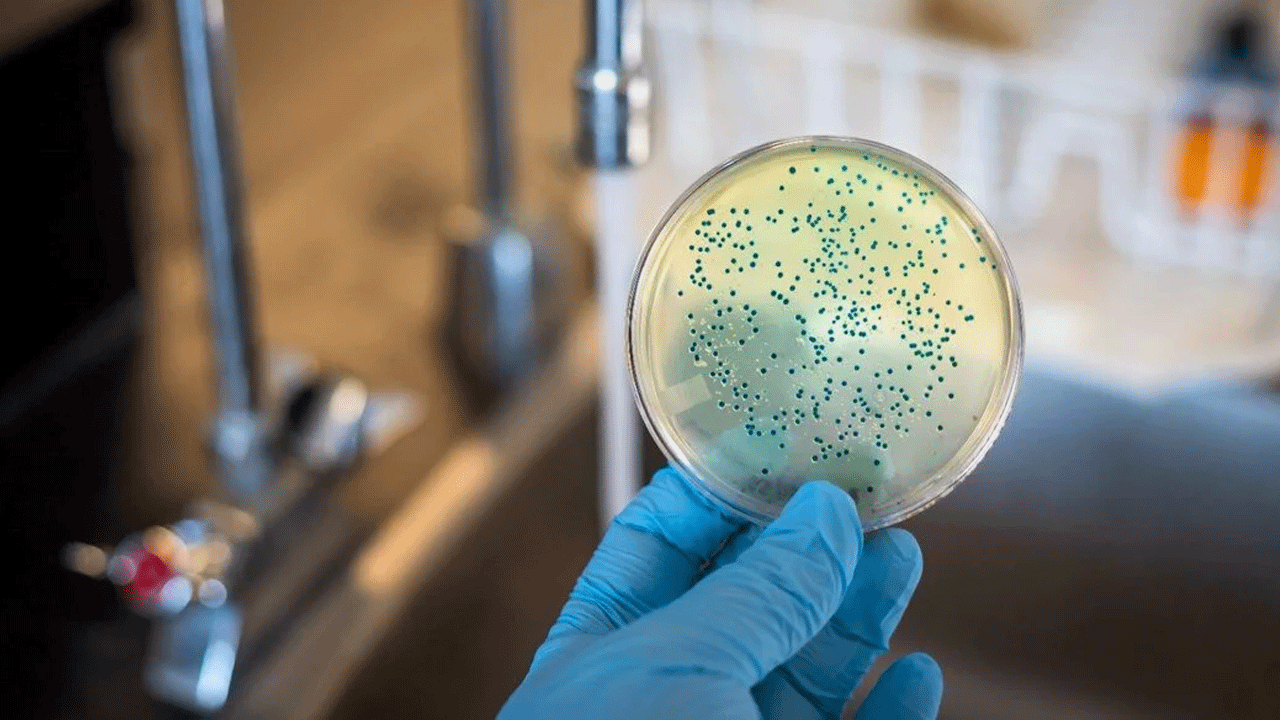
Foto - ABD'de alarm verildi: 4 kişi hayatını kaybetti!
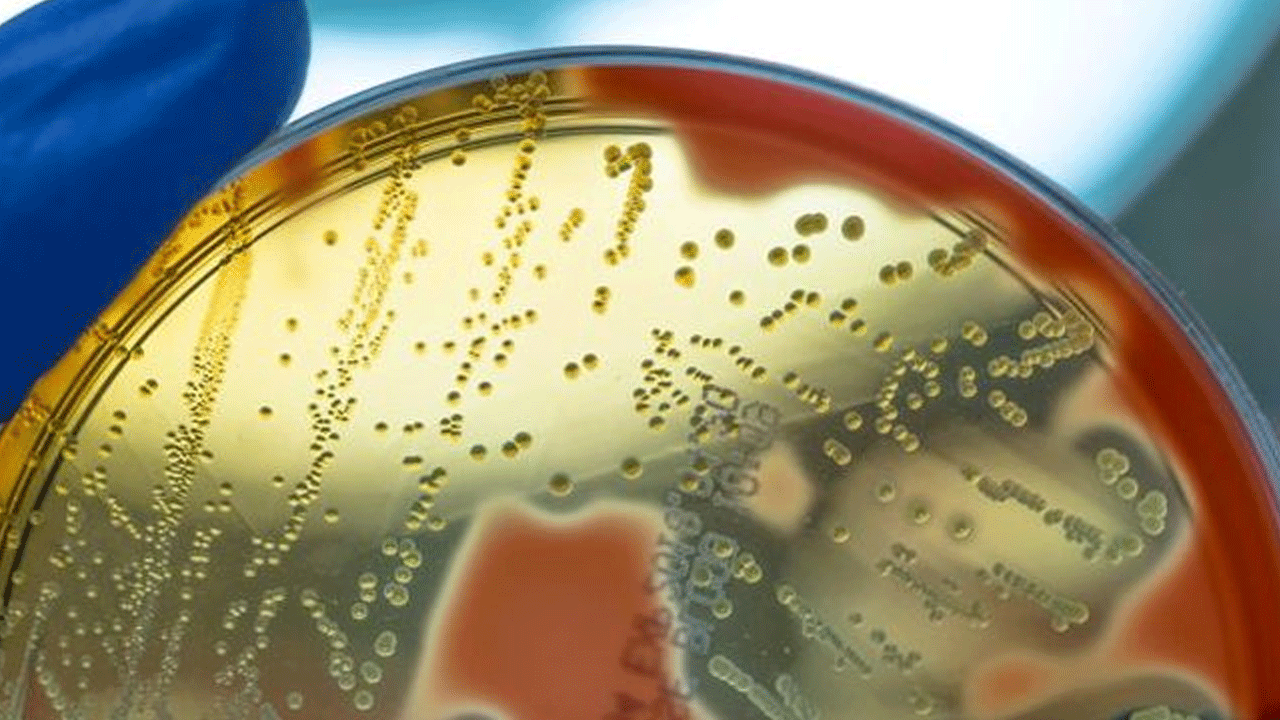
Foto - ABD'de alarm verildi: 4 kişi hayatını kaybetti!

ABD'de alarm verildi: 4 kişi hayatını kaybetti!
ABD'de, ılık ve tuzlu sularda yaşayan "et yiyen bakteri" Vibrio vulnificus nedeniyle bu yıl 4 kişi hayatını kaybetti. Bakteri, özellikle açık yaralardan vücuda girerek ölümcül enfeksiyonlara yol açabiliyor.